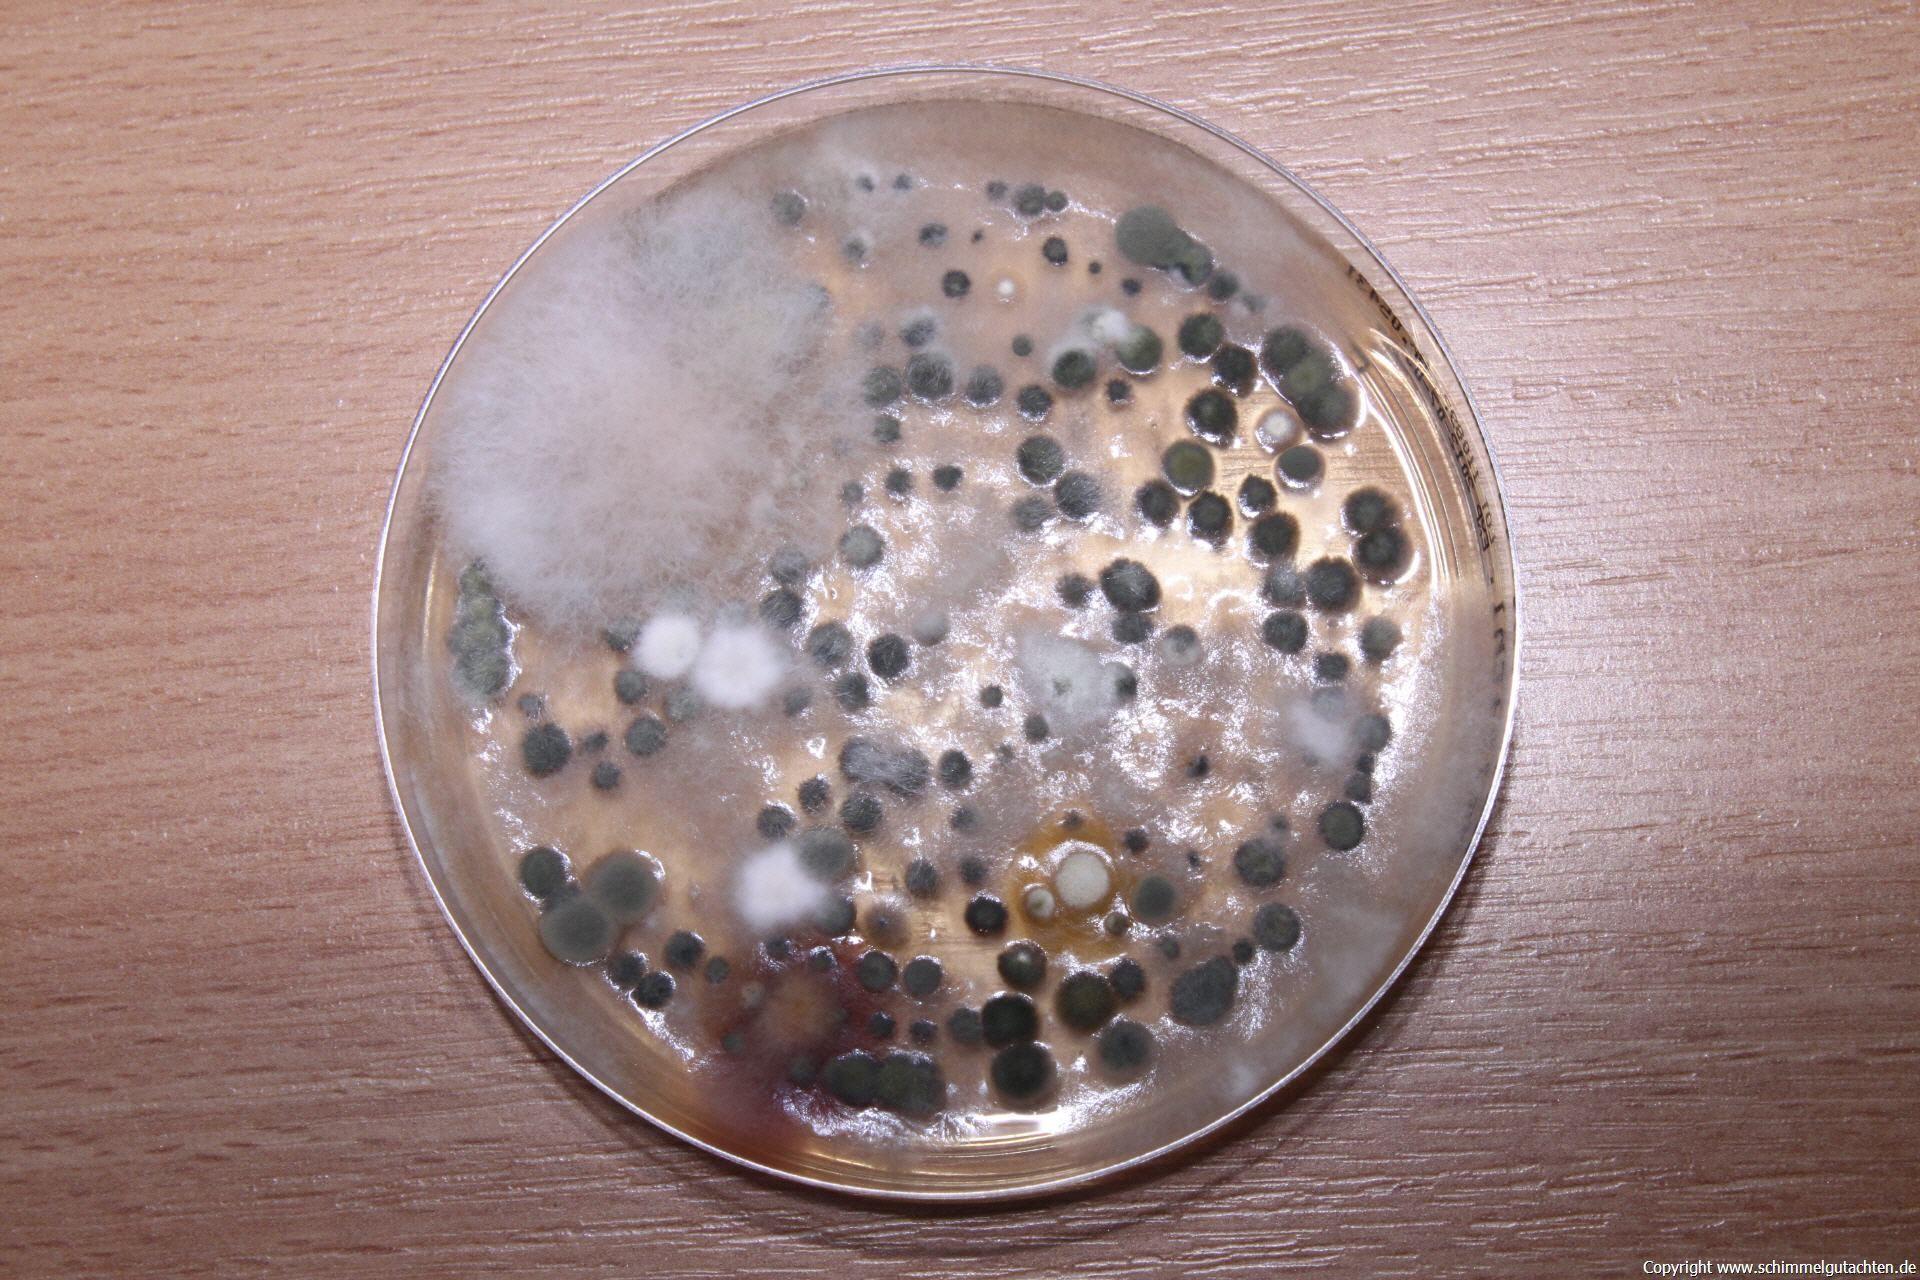

Fensterfalzlüftung
Eine kritische Betrachtung
Aktuell kommen alle paar Tage neue Artikel im Lexikon hinzu. Gerade haben wir einen zum Thema Fensterfalzlüftung veröffentlicht. Da uns diese technische Lösung, mit der eine ausreichende Luftundichtigkeit(!) in Neubauten hergestellt werden soll, immer häufiger begegnet und deren ausreichende Funktion oftmals angezweifelt werden muss, haben wir unsere Stellungnahme dazu veröffentlicht.


EM-Experten im Dialog
Der Sachverständige am Bau
Im aktuellen EM-Journal ist ein interview zu unserer Arbeit mit den effektiven Mikroorganismen erschienen.


Künstliche Intelligenz
So stelle ich mir das vor ....
Mein Auftrag an die "Künstliche Intelligenz" lautete: "Erstelle ein Bild mit einem echten Hausschwamm an einem Bilderrahmen". Das hier gezeigte Bild wurde erzeugt. Inzwischen habe ich eine ganze Sammlung von unsinnig beantworteten Fragen zum Thema Schimmelbildung, Schadstoffbelastungen und noch mehr solcher Bilder. Eine Auswahl der Kreationen dieser "Künstlichen Intelligenz" ist im nächsten Abschnitt zu sehen. Teilweise fragt man sich wo die KI den "guten Stoff" herhatte, welcher derartige Kreationen möglich macht. Auf jeden Fall ist mir neu, dass man die KI mit LSD dramatisch antörnen kann. :-)
Wir verlassen uns lieber weiterhin auf gute Fachbücher, Weiterbildungen bei erfahrenen Fachleuten und das eigene Hirn, statt auf die automatisierte Hilfe des Internets.
Für alle die nicht wissen, was ein echter Hausschwamm wirklich ist, können sich diesen gerne in unserem Lexikon ansehen.
Die Kreativität "künstlicher Intelligenz"
- Asbest in der Luft
- Holzschutzmittel an einem Dachbalken I
- echter Hausschwamm an Bilderrahmen
- holzzerstörender Pilz an einem Bilderrahmen
- Insektenfraß an einem Fachwerkhaus I
- Schadstoffe in der Wohnung I
- Schadstoffe in der Wohnung II
- Schadstoffe in der Wohnung III
- Schadstoffe in der Wohnung IV
- Schimmel an Fensterglas I
- Schimmel an Fensterglas II
- verschimmelter Käse in Tomatencremesuppe
- Wasserschaden im Bad I
- Wasserschaden im Bad II
- Wasserschaden im Bad III
- Wasserschaden im Bad IV
- Mobilfunkstrahlung I
- Mobilfunkstrahlung III


Traum und Wirklichkeit
Energieeinsparung durch Wärmedämmung
Wir haben uns schon vor vielen Jahren aus der Energieberatung verabschiedet, weil das was wir ausrechnen mussten mit der Realität oft kaum etwas zu tun hatte. Die Sanierungen, welche aufgrund unserer Berechnungen ausgeführt wurden, waren oft weit weniger effizient und die Kosten standen in keinem Verhältnis zu den angeblichen Einsparungen.
Ein interessantes Papier des Umweltbundesamtes zeigt die Gründe. Und diese sind keinesfalls überwiegend in dem stets unkalkulierbaren Nutzerverhalten zu suchen. Schlimmstenfalls liegen zwischen der berechneten Ersparnis und der Realität Differenzen von über 50 %, was auch erklärt, warum viele angeblich schlecht gedämmte Gebäude weitaus weniger Energie verbrauchen, als sie nach offiziellen Berechnungen müssten.
Lesen Sie selbst: Realitätsnahe Berechnung des Energiebedarfs
Um Missverständnissen vorzubeugen: Es ist grundsätzlich richtig und notwendig schlecht gedämmte Häuser, welche dazu auch noch sehr luftundicht sind, energetisch zu verbessern. Leider verhindern die politischen Vorgaben aber sehr häufig das rechte Augenmaß dabei. Bei einem Haus aus den 50-er Jahren des letzten Jahrhunderts in einem Durchgang Dach, Fenster und Fassade dämmen zu müssen, weil dies aufgrund dieser Vorgaben anders nicht möglich ist, ist oftmals wirtschaftlicher und energetischer Unfug. Besser wäre es aus meiner Sicht, den Hausbesitzern die Möglichkeit zu geben, all diese Maßnahmen nach und nach in einem vernünftigen Maß durchführen zu lassen. Nicht jeder kann auf einmal einen riesigen Betrag investieren. Aber kleine Schritte in die richtige Richtung würden sowohl der Umwelt als auch dem eigenen Geldbeutel oftmals mehr helfen, als nichts zu tun, weil den Hauseigentümern hierfür schlichtweg das notwendige Geld fehlt.


Seminare, Workshops, Vorträge
Der Terminkalender füllt sich
Für das kommende Jahr stehen bereits 6 Termine fest, an denen Sie die Möglichkeit haben, von unseren Erfahrungen rund um das Thema Baubiologie und Bauphysik zu profitieren. Sie finden diese auf unserer Webseite unter Veranstaltungen.
Weitere Themen sind in Planung, so dass unser Angebot noch umfangreicher werden kann. Wenn Sie informiert bleiben wollen, melden Sie sich einfach auf dieser Seite rechts zum Newsletter an.


Pisa Schock? Oder vorhersehbare Folgen der ungehemmten Digitalisierung?
Deutschland als Entwicklungsland?
Wenn man sich, wie ich, seit über 35 Jahren mit den Auswirkungen von Schadstoffen und Strahlungen auf den Menschen beschäftigt, wird man es oftmals leid, immer wieder das Selbe zu predigen. Mit vielem habe ich mich inzwischen arrangiert und verzichte darauf, andere überzeugen zu wollen. Was ich aber nicht aufgeben werde, ist mir Gedanken um unsere Nachkommen zu machen. Als reiferer Geselle erlebe ich wachsende Verblödung unserer Gesellschaft und das oft nur noch instinktgetriebene Handeln vieler Zeitgenossen immer stärker. Die Aufmerksamkeitsspanne von uns allen wird immer geringer, insbesondere bei den Kindern. Das Lesen von Büchern oder längeren Zeitungsartikeln ist vielen nicht mehr möglich. Das Erfassen von komplexen Zusammenhängen, die Entwicklung von Wissenshunger und Neugierde bleibt bei vielen auf der Strecke. Lieber richten wir uns darauf ein, zukünftig von sogenannter künstlicher Intelligenz denken zu lassen. Meine diesbezüglicher Versuch, mehrere Fachfragen aus meinem Tätigkeitsbereich beantwortet zu bekommen, brachte ausschließlich(!) falsche Ergebnisse. Gruselig!
Im Ausland ist man in vielen Bereichen schneller und bewusster beim Umgang unserer Kinder mit digitalen Medien. Hier wird der Umgang der kleinsten hiermit verboten oder zumindest stark reglementiert. Nur bei uns setzt man noch immer völlig ungehemmt auf die Digitalisierung kindlicher Hirne. Deutschland als Entwicklungsland? Wenn's so weitergeht.... prost Mahlzeit!
Ein schöner Artikel ist gerade hier Erschienen: Pisa-Schock: Was sagt die Hirnforschung zur Bildungskatastrophe und zur Digitalisierung des Lernens von Kindern und Jugendlichen?
Und hier der Schriftwechsel zu dem Artikel zwischen Frau Prof. Teuchert-Noodt und einer Lehrerin: Sind die negativen Auswirkungen der Smartphone-Nutzung auf die Gerhirnentwicklung von Kindern therapierbar?
Ein weiterer Artikel, der durchaus zum darüber nachdenken geeignet ist: Nichts wird sich ändern ....
Und eine gute DVD zum Thema gibt es auch: Aufwach(s)en im Umgang mit digitalen Medien

Energiesparen kann so einfach sein
Die Heizsaison hat begonnen
Wer eine erhebliche Menge an Heizenergie sparen will sollte vor Beginn der Heizsaison seine Heizkörper von Staubablagerungen befreien, denn diese mindern auf zweierlei Arten die Wärmeübertragung an die vorbeiströmende Luft. Zum einen wirkt der Staub wärmeisolierend und zum anderen bremst er die Strömungsgeschwindigkeit, so dass die Effizienz der Energienutzung um über 10% abnehmen kann. Nebenher steigt auch das Risiko der Schimmelbildung an den Wärmebrücken. Je geringer die Luftverwirbelung in den Räumen ist, desto geringer können die kritischen Stellen im Bauwerk erwärmt werden. Je nach Heizkörper gibt es spezielle Bürsten im Fachhandel., mit denen der Staub ohne großen Aufwand entfernt werden kann. Damit sich der Staub nicht in der ganzen Wohnung verteilt sollte man das Staubsaugerrohr in die Nähe der Bürste halten oder nass arbeiten. Das unten am Heizkörper austretende Wasser muss natürlich aufgefangen werden. Am einfachsten geht dies mit einem großen Handtuch.


Energiesparen ohne Schimmelbildung?
Es klappt, auch wenn man es ein Wenig übertreibt
Im letzten Winter trieb viele von uns die Angst um, dass wir uns die Energiekosten nicht mehr leisten können. Und wir selbst befürchteten einen enormen Anstieg bei den Aufträgen, bei denen wir uns um die Ursache für einen Schimmelbefall kümmern sollten. Meine Familie und ich haben gleichzeitig beschlossen, im Selbstversuch herauszufinden, wie stark wir Energie sparen können, ohne dass wir all zu sehr beeinträchtigt werden und ohne dass sich Schimmel bildet. Zugegebenermaßen war das oft nicht sehr komfortabel, aber es hat geklappt. Wir konnten in einem nicht sanierten, luftundichten Altbau über 1/3 der Energie einsparen (links in der Grafik die Abrechnung 2021 und rechts die Abrechnung 2022), ohne dass wir all zu sehr eingeschränkt wurden und ohne dass sich Schimmel gebildet hat. Das Geheimnis? Auch kalte Wohnungen gehören regelmäßig gründlich gelüftet.
Dies haben viele nicht bedacht, was sich in den Aufträgen Anfang des Jahres gezeigt hat. Während wir in den vergangenen Jahren bei Schimmelschäden überwiegend Probleme baulicher Natur fanden, war dies in der letzten Saison genau umgekehrt.
Wir sind auf die kommende Saison gespannt.


Allgemeine Grundlagen für die Schimmelsanierung
Unser Merkblatt - Neu überarbeitet
Und wieder einmal wurde es Zeit, unser Merkblatt zu überarbeiten. Sowohl Auftraggeber wie auch Auftragnehmer finden hierin viele Hinweise, wie sie sich Aufwand und Ärger ersparen können und mit größtmöglicher Sicherheit zum gewünschten und (hoffentlich auch) vereinbarten Sanierungsziel kommen.


Frühdigitalisierung bei Kindern schadet Ihrer Entwicklung
Die Gehirne unserer Kinder benötigen mehr als bits und bytes
Das Webportal diagnose:funk macht darauf aufmerksam, dass ein Nachbarland die Frühdigitalisierung der Kinder stoppt, weil die Risiken und Nebenwirkungen zu groß sind.
Zitat: "Die Rückmeldungen der WissenschaftlerInnen waren deutlich: Kleinen Kindern sollten gar keine Bildschirme vorgesetzt werden. Und in der Schule sei physisches Spiel dem digitalen Spiel vorzuziehen. Kinder würden so das soziale Zusammenspiel eher lernen. Zudem würde das Sprachvermögen gestärkt und Kindern lernten besser, sich in andere hineinzuversetzen."
Den ganzen Artikel und viele weitere Informationen zu dieser Thematik finden Sie unter www.diagnose-funk.org.


Brummtöne und Brummgeräusche
Tiefe Frequenzen, welche die Gesundheit belasten
Tiefe Frequenzen können unwahrscheinlich nervig und hierdurch gesundheitsschädlich sein. Seit vielen Jahren beschäftigen wir uns mit der Thematik und es wurde Zeit auch hierzu einen Artikel in unser Lexikon zu stellen.


Alle reden über das Klima
und denken doch nicht an alle Bereiche
... und jeder will, dass sich dort etwas ändert, aber bitte nur dort, wo es ihm selbst am wenigsten weh tut. Gleichzeitig ist es schick, dem Verbraucher angebliche Klimaneutralität vorzugaukeln. Dass dies nicht funktionieren kann und auf geschönten Zahlen beruhen muss kann jeder erahnen, der sich die vielen Labels und Versprechungen mal genauer ansieht.
Eine riesige Einsparmöglichkeit an Co2, Abwärme, Ressourcen etc. besteht beim Internet und beim Mobilfunk. Aber da will keiner wirklich etwas ändern. Dafür sind wir alle von dieser Technologie zu abhängig geworden.
Wussten Sie:
- Wäre das Internet ein Land, wäre es der sechstgrößte Stromkonsument auf dem Planeten.
- Digitale Technologien sind aktuell für 3,7 Prozent der Treibhausgasemissionen verantwortlich – das ist mehr als der internationale Flugverkehr verursacht.
- Davon entfallen ganze 80 Prozent auf Video-Streaming. Video-on-Demand allein erzeugt dabei so viel Treibhausgas wie ganz Chile (über 100 Megatonnen CO2 pro Jahr).
- Künstliche Intelligenz gilt als der nächste große Stromfresser unter den neuen Technologien.
- Allein In Deutschland gibt es mehr als 53.000 Rechenzentren mit über 2 Millionen Servern.
- Durch die Einführung von 5G könnten bis zu 3,8 Milliarden Kilowattstunden zusätzlich an anfallen.
- Nur 19 Prozent der weltweiten Rechenzentren verwenden Teile ihrer Abwärme weiter.
- Frankfurt ist die Rechen-Hauptstadt des Landes mit über 600.000 Quadratmetern an betriebenen Rechenzentrumsfläche.
(Quelle: https://www.eon.com/de/ueber-uns/green-internet.html)


Schimmelschäden vermeiden in Zeiten der Energiekrise
Vortrag für Hausverwaltungen
Eigentlich wollten wir keine Fortbildungen mehr in Eigenregie anbieten. Aber besondere Zeiten erfordern eben besondere Maßnahmen. Für Immobilienverwalter haben wir einen speziellen Vortrag erarbeitet, um sie auf den kommenden Winter und die sich aus den notwendigen Energieeinsparungen heraus ergebende Problematik, vorzubereiten.
Am 01.12.2022 werden wir Sie über die Risiken des Energiesparens informieren, Ihnen Optimierungshilfen bei der Beheizung und der Warmwasserbereitung aufzeigen und Ihnen reichlich Tipps mitgeben, welche Sie an die Wohnungsnutzer weitergeben können.
Für Getränke und Snacks ist gesorgt. Der Kostenbeitrag beträgt € 15,--.
Da die Teilnehmerzahl begrenzt ist raten wir zu einer schnellstmöglichen Anmeldung.


Der Winter naht ....
... und wir alle wollen den Energieverbrauch senken.
Leider wird dies nicht ohne Nebenwirkungen bleiben. Beispielsweise lässt das Absenken der Raumtemperatur die Schimmelgefahr enorm steigen. Der Grund liegt u. A. darin, dass ausgekühlte Wohnungen seltener gelüftet werden und Wasserdampf in kalten Umgebungen schneller auskondensiert. In schlecht gedämmten Häusern ist die Gefahr einer Schimmelbildung auf den kalten Oberflächen hierdurch besonders hoch. Wer wenig heizt muss seine Wohnung daher häufiger kurz stoßartig querlüften - auch wenn dies die Gefahr erhöht, dass die Innenraumluft hierdurch noch kälter wird. Je kürzer der Lüftungsvorgang ist, desto weniger kühlen die Oberflächen weiter aus. Daher ist es besser, wie voran beschrieben häufig, bei mehreren weit geöffneten Fenstern und offenen Zimmertüren zu lüften, als längere Zeit nur ein Fenster (in Kippstellung) zu öffnen.
Wichtig ist auch die Hygiene. Je sauberer die Räume sind desto weniger Schimmelsporen können sich im Hausstaub ablagern. Daher sollten alle Oberflächen der Räume regelmäßig von Staub befreit werden, um das Risiko weitmöglichst zu senken. Das sich die Sporen im Feinstaub verbergen kommen hierfür nur Verfahren in Betracht, welche auch diesen aufnehmen. Am einfachsten geht dies mit feuchten oder mit elektrostatisch aufgeladenen Tüchern. Wer kann sollte auch hinter den Schränken, in den Heizkörpern an den Wandoberflächen etc. für größtmögliche Sauberkeit sorgen.
Unbedingt sollten alle Zimmer gleichmäßig beheizt werden. Lässt man einzelne Räume auskühlen besteht in diesen ein deutlich erhöhtes Risiko eines mikrobiellen Befalls.
Wichtig ist auch, dass die Luft an den kältesten Stellen des Raumes gut ausgetauscht werden kann und die Heizkörper nicht zugestellt (z. B. durch Sofas) oder verhangen werden. Im Altbau kann es auch helfen, wenn die Heizkörpernischen mit alukaschiertem Dämmmaterial, welches es in den Baumärkten zu kaufen gibt, ausgekleidet wird.
Diese Tipps helfen nur allgemein weiter. Wer Hilfe für spezielle bauliche oder nutzungsbedingte Situationen benötigt kann sich gerne an uns wenden.


Grundlagen für die Schimmelsanierung
Neues Merkblatt erschienen
Aktuell haben wir leider keine Kapazitäten mehr, unsere eigenen Seminare und Vorträge anzubieten. Im Herbst sind dafür zwei Seminare an der WTA-Akademie zum Thema Klimaoptimierung und die Schadstoffbelastungen in historischen Bauwerken geplant. Weitere Seminare und Vorträge bei anderen Veranstaltern sind in Planung.

Sanierung von Schimmelpilzschäden
Neues Merkblatt erschienen
Es wurde wieder einmal Zeit, unser Merkblatt für die Schimmelsanierung zu aktualisieren. Inzwischen wurden mehrere grundlegende Richtlinien überarbeitet und auch unsere Erfahrung ist weiter gewachsen. Dies wurde in der Neuauflage berücksichtigt.


Wir sind angekommen!
Endgültig!
Anfang des Jahres sind wir in unser neues Domizil gezogen und seit heute ist das nicht mehr zu übersehen -> Die Außenwerbung wurde montiert.


Großer Preis des Mittelstandes 2022
und wir sind nominiert
Wir waren sehr überrascht und haben uns noch mehr gefreut, als wir dieser Tage informiert wurden, dass wir es auf die Nominierungsliste geschafft haben. Dabei wussten wir bis dahin gar nicht, dass es so was gibt.
Leider sind aber wir noch(!) zu klein, um daran teilnehmen zu können. Aber wir arbeiten fleißig daran und hoffen, dass wir ganz bald die Voraussetzungen erfüllen. Unterstützen Sie uns dabei, indem Sie an unserem Erfolg mitarbeiten! -> Wir suchen Mitarbeiter!

Schimmel und Polyvinylacetat
2 neue Artikel in unserem Lexikon
In unserem Lexikon haben wir einen Artikel zum Thema Feuchte und Schimmel in Fahrzeugen veröffentlicht.
Anfragen zu dem Thema haben wir das ganze Jahr über, da die Auswirkung von Undichtigkeiten oft erst mit großer zeitlicher Verzögerung festgestellt werden. Abhilfe ist auch hierbei möglich, wenn man weiß wie es geht.
Und beim anpassen der Homepage ist uns noch ein weiterer, bisher unveröffentlichter Artikel zum Thema Polyvinylacetat aufgefallen. Er ist nun ebenfalls online.


Masken schützen!
wenn alles stimmt....
Wird eine FFP2-Maske vom Träger richtig angelegt, bietet sie sowohl dem Träger als auch seinem Umfeld gegenüber ein recht hohes Schutzniveau, wie auf obigem Bild zu sehen ist.
Bedenken sollte man, dass sich Leckagen im Material (zulässig sind in der Prüfung 6%) und zusätzliche seitliche Leckagen (zulässig sind in der Prüfung 11%) nicht ausschließen lassen und in der aktuellen Lage die größtmögliche Sicherheit nur der bewusste Umgang mit der allgemeinen Situation und die gegenseitige Rücksichtnahme darstellen - und das völlig unabhängig vom Impfstatus.


Klickvinyl - Gut oder Schlecht oder?
Wir haben wieder einmal einen größeren Artikel veröffentlicht.
Dieses mal geht es um das Thema PVC, welches zwischenzeitlich auch einfach als Vinyl bezeichnet wird. Klingt das nur besser oder ist es das auch?


DVD: Das Aufwach(s)en mit digitalen Medien
Das Eltern und Erzieher wissen sollten: Dieser Film zeigt, wie der frühe Gebrauch digitaler Medien die Gehirnentwicklung beeinflusst.
Er richtet sich an alle, die Kinder pädagogisch begleiten. Es ist ein Film für Eltern, Lehrer, Erzieher sowie Fachkräfte in der psychologischen und ärztlichen Praxis, die mit den Auswirkungen des digitalen Medienkonsums konfrontiert sind.
Wie verträgt sich der Einsatz von digitalen Medien mit Bewegungsdrang, mit freiem Spielen und dem Entdecken des kindlichen Kosmos? Wie werden Kinder und Jugendliche medienmündig? Spielerisches Lernen und Sinneserfahrungen in der realen Welt schaffen die Grundlage, um später als Erwachsener mit Gefühlen, Wünschen und Frustrationen umgehen zu können und das Leben zu meistern.
Diagnose:Funk hat diesen Film entwickelt, um Eltern und ErzieherInnen in diesen anstrengenden und schwierigen Zeiten besonders beizustehen. Und vor allem: Wie es gelingen kann, dass Kinder und Jugendliche medienmündig werden.
Drei zusätzliche Bonustracks und Grundlagenartikel (s. Downloads auf der Seite von Diagnose:Funk) liefern wissenschaftliche Vertiefungen, die den Film für Kita- und Schulkollegien, Lehramts-, Fach- und Hochschulseminare und Workshops zu einem idealen Fortbildungsmedium machen.
Der Film zu nachfolgendem Trailer ist hier erhältlich
Dieser Inhalt kann leider nicht angezeigt werden, da Sie der Speicherung der für die Darstellung notwendigen Cookies widersprochen haben. Besuchen Sie unser Cookie-Kontrollzentrum, um Ihre Cookie-Präferenzen anzupassen.
Sollten Sie uns Ihre Einwilligung gegeben haben und die Seite funktioniert dennoch nicht, aktualisieren Sie die Webseite bitte.


Covid-19
Fragen? Antworten?
Wahrscheinlich führt alleine das Aussprechen des Begriffs bald zu allergischen Reaktionen. Dennoch müssen wir alle uns weiter damit beschäftigen. Um selbst mehr Klarheit zu bekommen haben wir daher unseren Erkenntnisstand in einem kurzen Artikel zusammengefasst. Lesen Sie ihn -> hier.


Künstliche Mineralfasern (KMF)
Auch dieser Artikel war stark "in die Jahre gekommen" und musste dringend überarbeitet und erweitert werden. Das Resultat finden Sie hier.
(Obiges Foto: GBA Mönchengladbach)


Allgemeine Grundlagen für die Schimmelsanierung
Die letzte Version unserer allgemeinen Grundlagen für die Sanierung von schimmelbelasteten Innenräumen stammte noch aus 2016. Es wurde dringend Zeit diese wieder einmal zu überarbeiten. Die aktuelle Fassung finden Sie hier.


Feuchteschäden, Schimmelbildung, Holzzerstörer
Klimaoptimierung in Kirchen
Im Rahmen des E&Kik-Programms der Erzdiözese Freiburg stellen wir aktuell die Ergebnisse unserer gutachterlichen Arbeit in 7 Kirchen vor.
Jede der untersuchten Kirchen ist in ihrer Problematik unterschiedlich und bedarf ebenso unterschiedlicher Hilfe, damit das Klima dort so optimiert werden kann, dass dem Inventar, den Besuchern, der Minderung der Betriebskosten und dem Umweltschutz bestmöglich gedient ist.
Tätigkeiten im Denkmalschutz sind immer wieder eine spannende Herausforderung, der wir uns gerne stellen.


Feuchteschäden, Schimmelbildung, Holzzerstörer
Ein neuer Artikel in unserem Lexikon
Für Schäden, welche durch Wasser und Feuchte ausgelöst werden gibt es viele mögliche Ursachen. Unser neuer Artikel dazu soll eine erste Orientierung (ohne Anspruch auf Vollständigkeit) ermöglichen.

Vorbeugende Hygiene im Haushalten
Ein wichtiger Teil der Coronavorsorge
Aus aktuellem Anlass haben wir einen älteren Artikel überarbeitet und ergänzt.
Der Beste Schutz vor unerwünschten Ereignissen ist stets die Vorbeugung.
Corona ist in aller Munde - aber zum Glück (noch) nicht in aller Körper..
In unserem Artikel "Hygiene im Haushalt"finden Sie wichtige Tipps,. die Ihr persönliches 'Risiko durch einfach Maßnahmen senken können.


Praktische Erfahrungen sind oft wichtiger als theoretisches Wissen
Versuch macht kluch :-)
Seit vielen Jahren probieren wir unterschiedlichste Verfahren bei der Sanierung selbst aus, um die Möglichkeiten und Grenzen der Verfahren kennenzulernen..
So arbeiten wir bei der Geruchsbekämpfung schon seit über 10 Jahren mit der Ozonierung, der Ionisation und der Nutzung effektiver Mikroorganismen.
Seit kurzem haben wir für die Messung der Ionisierung endlich ein sehr hochwertiges Messgerät und können den Erfolg unserer Arbeit noch besser überwachen.
Und weil uns das so viel Spaß macht bereiten wir gerade Messkammern vor, in denen wir unter kontrollierten Bedingungen (Ionen, Ozon, Temperatur, Feuchte, Luftdruck, etc.) Keimversuche und Schadstoffminderungen durch die Ionisierung erfassen können. Wir werden berichten.


Der Schweizer Rückversicherer SWISS RE, der zu den weltweit größten Versicherern gehört, warnt vor dem neuen Mobilfunkstandard 5G
Mobilfunkstandard 5G nicht ohne Risiko
In Ihrem aktuellen Sonar-Bericht 2019 schreibt die Versicherung:
"Die Digitaltechnologie prallt auf die bestehende Infrastruktur, mit der Folge neuer Risiken durch die Verbreitung von 5G-Mobilfunknetzen, zunehmend eingeschränkter fiskalischer und geldpolitischer Flexibilität sowie Gentests und ihre Auswirkungen auf die Versicherungswirtschaft sind Herausforderungen mit potenziell hohen Auswirkungen....".
Außer Kontrolle (von der Leine): Die Verbreitung der 5G-Technologie
5G wird die drahtlose Konnektivität in Echtzeit für jedes Gerät des Internets der Dinge (IoT) ermöglichen, wie beispielsweise autonome Autos oder sensorgesteuerte Fabriken. Die derzeitigen Bedenken hinsichtlich möglicher negativer gesundheitlicher Auswirkungen elektromagnetischer Felder dürften zunehmen. Darüber hinaus können Hacker auch die Geschwindigkeit und das Volumen von 5G nutzen, um schneller mehr Daten zu erfassen (oder zu stehlen). Zu den größten Bedenken gehören mögliche Datenschutz- und Sicherheitsverletzungen sowie Spionage."
Den englischen Originaltext finden Sie hier.


Ab sofort erstellen wir 360° Panorama Aufnahmen
Alle Details im Rundumblick
Egal ob Schäden dokumentiert, Wertgutachten erstellt oder der Immobilienverkauf erleichtert werden soll - mit 360° Aufnahmen entgeht dem Betrachter nichts. Wir erstellen für Sie Dokumentationen, virtuelle Touren und Beweissicherungen mit unserer 360° Panorama Kamera.


HF-Messgeräte im Vergleich
Auf der Suche nach Erkenntnis
Immer wieder stellt sich die Frage: Wie genau sind unsere Messgeräte, wie stark weichen sie untereinander ab und wie sind die Messwerte zu interpretieren?
Mit unserem Kollegen Daniel Herbold bin ich schon einige Nächte daran, ein tieferes Verständnis für die Zusammenhänge zu entwickeln, um die Ergebnisse besser vergleichen und interpretieren zu können.
Nebenher tauchen dabei Übersetzungsfehler in den Anleitungen, rätselhafte Kennlinien für mitgelieferte Antennen und mehr auf.
Da Bild zeigt eine Auswahl der uns zur Verfügung stehenden Messtechnik. Der große Specci war schüchtern und wollte nicht mit auf das Bild.
Spannend ist das allemal. Wir bleiben dran.

Strahlungsarme Smartphones
Die Gesundheit beim Telefonieren bestmöglich schützen
Die Zeitschrift Connect veröffentlicht regelmäßig eine aktuelle Liste strahlungsarmer Handys als PDF. Wer nicht nur auf Design und Funktionalität setzt sondern auch seine Gesundheit schützen will ist hiermit gut beraten


Schimmel in Kirchen und an deren Inventar
Klimaoptimierung in Kirchen
Zwischenzeitlich ist die zweite erweiterte und überarbeitete Auflage unserer umfangreichen Schrift zum Thema Schimmel in Kirchen und an deren Inventar erschienen.
Wir haben darin unsere Erkenntnisse aus vielen Untersuchungen dieser besonderen Gebäude zusammengefasst und geben darin Hinweise, wie feuchtebedingte Schäden zu vermeiden und Sanierungen durchzuführen sind.
Gerne können Sie diese bei uns kostenlos bestellen - eine kurze Email mit Ihren Adressdaten reicht.


Forschungslage Elektromagnetische Felder - Schwerpunkt Mobilfunk
Gute Datensammlungen zur Belastung durch Elektrosmog
Auf der Seite www.EMFdata.org hat die Umwelt- und Verbraucherschutzorganisation diagnose:funk relevante Studien und Dokumentationen als Datenbank veröffentlicht.
Die Online-Datenbank soll einen wesentlichen Beitrag zur Aufklärung der Bevölkerung und Politik leisten.

Wann haben Sie das letzte Mal einen richtig schönen Sternenhimmel gesehen?
Und wo ist es dunkel genug dafür?
Auf der Seite www.darksitefinder.com wird die Lichtverschmutzung, welche immer mehr selbst in klaren Nächten für einen scheinbar sternlosen Himmel sorgt, eindrucksvoll dargestellt.
Eine Reise in einen dunklen Bereich (einfach Ihren Wohnort unter Search eingeben, und dann aus der Karte herauszoomen) lohnt sich und zeigt eindrucksvoll, welche Schönheit uns zwischenzeitlich jeden Abend entgeht.